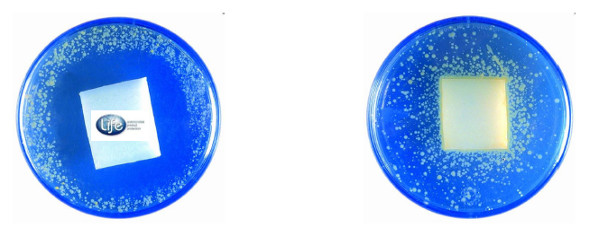

感谢您访问我们的网站,您可能还对以下资源感兴趣:通辽岛笔机械设备有限公司
日韩精品一区二区我不卡影院,色欲国产精品一区成人精品
,女人被狂躁到高潮视频免费动态图
,av人摸人人人澡人人超碰妓女,青青草a国产免费观看,黄色wwww,欧美日韩第一页,激情网站
网站地图
色噜噜狠狠色综合欧洲
久久天堂av色综合
久久国产精品快射视频
操亚洲无码
最近最新中文字幕免费的一页
国产麻豆天美果冻无码视频
第一页在线
A片免费在线观看
成人无码区免费A片在线软件
亚洲%20欧美日韩%20综合%20国产
国产又爽又黄无码无遮挡在线观看
91精产国品一二三区
三级在线视频观看
国产麻豆天美果冻无码视频
欧美亚洲国产日韩一区二区
成人特级毛片WWW免费版
婷婷久久综合九色综合97最多收藏
亚洲熟女少妇av一区
国产偷国产偷高清精品
蜜臀av亚洲一区二区
国产精品久久精品第一页
久久夜色精品国产网站
午夜伦理福利
亚洲第一页乱
亚洲综合伦理一区三区
久久久久久久波多野结衣高潮
人妻久久久一区二区三区
日本一卡二卡四卡无卡国产
亚洲精品1区2区
精品国产大片中文字幕
97人妻人人揉人人躁人人
中文字幕一区中文亚洲
国产日韩欧美亚洲综合首页
亚洲婷婷综合中文字幕第一页
a亚洲欧美中文日韩在线v日本
国产女主播精品一区二区三区
a在线亚洲男人的天堂试看
亚洲欧美另类中文字幕
中文字幕日韩高清一区
熟女乱伦电影
玖玖爱视频在线观看
日韩精品一区二区三区大桥未久
无码av无码免费一区二区
亚洲国产不卡av一区二区三区
久久精品毛片av一区二区三区
岛国av免费
久久久久亚洲Av片无码一区
欧美一区二区三区成人片在线
四虎影音亚洲无码
天天综合网久久网亚洲
亚洲美腿丝袜福利一区
久久国内偷拍综合视频
好大好硬好湿好爽再深一点视频
亚洲欧美精品中文第三
亚洲中文字幕乱码一二三区
日日摸夜夜添夜夜添无
天天综合天天添夜夜添狠狠添
欧美成人AA视频免费观看
国产第1页
亚洲婷婷五月
呦交小U女精品视频
久久WWW成人看片免费不卡
中文字幕v亚洲ⅴv天堂
收集最新中文国产中文字幕
四虎精品国产永久免费
国产在线拍揄自揄拍无码
亚洲AV区
国产AV天堂亚洲国产AV天堂
伊人导航
人妻人人澡人人添人人爽人人玩
亚洲天堂一区
羞羞麻豆国产精品1区2区3区
中文字幕国产精品二区
久章草在线毛片视频播放
色噜噜狠狠色综合免费视频
亚洲MV国产MV在线MV综合试看
av无码中出一区二区三区
日本熟妇色一本在线观看
国产免费无遮挡吸奶头视频
久一有码中文字幕在线
免费av在线播放观看
成a人v欧美综合天堂
99国产视频
色噜噜狠狠色综合成人网
一区二区在线视频免费观看
国模少妇无码一区二区三区
中文字幕欧美人妻精品一区
看污网址
国产成人无码VA在线观看
国内精品vA久久久久中文字幕
99久久精品国产都在这里
青青青国产视频手机
国产精华AV午夜在线
精品人妻中文字幕在线
亚洲国产区最新地址
日逼视频网站
少妇人妻挤奶水中文视频毛片
男人桶女人18禁止网站
福利社AV
亚洲,一区二区三区精品视频
极品人妻少妇一区二区
亚洲一区无码中文字幕乱码
97久久久久久久久久久一区二区三区
亚洲 制服 丝袜 无码
日日摸夜夜爽-
亚洲一级毛片免费观看
少妇下面好紧好多水真爽播放
久久久久久免费视频
久久国产精品免费一区下载
精品国产AV色欲果冻传媒
中文字幕丰满乱子无码视频
久久高清超碰AV热热久久
中文字幕在线观看2018
最新成免费人久久精品
国产成人AV在线播放不卡
亚洲乱码av中文一区二区
国产熟妇婬乱一区二区
五月天成人小说
无码av秘?一区二区三区电车
国产麻豆精品传媒av国产
福利导航大全
国产激情久久久久久熟女老人
日韩有码玖玖资源中文字幕人妻不卡
日韩av一区二区三区
国产成人影院一区二区三区
www免费视频
超碰97成人
2022亚洲男人天堂
春色福利导航
高清无码一区二区三区
天天爱天天做天天爽
亚洲欧美精品成人久久91
久久国产精品久久精
亚洲精品乱码久久久久久蜜桃图片
亚洲国产日韩在线人高清 磁力
视频在线只有精品日韩
久久久久久99精品热久久
丝袜美腿一区二区三区
a片无码高清免费视频播放
97操逼
性色欲情网站
午夜性爱福利
精品精品国产欧美在线
国产高清JAPANESE在线播放E
婷婷久久综合九色综合88
国产一区在线视频观看
特黄免费
国产高潮流白浆喷水免费网站
久久综合无码中文字幕无码ts
色综合久久久高清综合久久久
三级性爱视频
无码精品黑人一区二区三区
无码日韩做暖暖大全免费不卡
性俄罗斯牲交XXXXX视频
亚洲AV成人无码久久精品
国产内射一级一片内射高清视频
五月婷婷丁香
韩国午夜三级一区二区
高潮喷水白浆在线观看
国产97公开成人免费视频
国产精品无码影视久久久久久久
艾小青国产精品40分钟
少妇50p
国内少妇高潮嗷嗷叫在线观看
国产精品一卡二卡三卡
日韩成人无码片av网站
成人免费av在线播放
538任你爽精品视频国产
国产一区曰韩二区欧美三区
99热这里只有精品免费推荐
首页 综合国产 亚洲 丝袜日本
人妻熟妇乱又伦精品无码专区
97不卡
亚洲天堂激情av在线
熟女人妻精品一区二区视频
6080**在线毛片
国产AV无码专区亚洲精品
日产无码精品一区二区三区
日本三级电影网
欧美综合区自拍亚洲综合绿色
欧美综合天天夜夜久久
西西444www高清大胆
91久久精品无码人妻系列
国产亚洲中文字幕一区二区
色欲91
黄床大片免费30分钟国产精品
亚洲国产亚洲综合在线尤物
天天躁夜夜躁狠狠躁图片
久久人人爽人人爽人人片aV东京热
99精品国产99久久久久久97
激情综合婷婷丁香五月
欧美高清性
久久精品中文字幕少妇
99久热在线精品视频
免费欧洲美女牲交视频
688欧美人禽杂交狂配
日韩亚洲精品中文字幕
天天综合亚洲色在线精品
亚洲无码天堂
亚洲人成在线免费观看
欧美中出无码
欧美wwww
国产精品被窝福利一区
啄木乌AV无码精品
久热av在线免费播放
精品国产亚洲av三区
91无码丝袜
久久中文字幕人妻丝袜系列
18视频网站在线观看
亚洲精品日本一区二区三区
国产乱子伦手机在线
国产目拍亚洲精品二区
久久偷拍视频只有精品
亚洲成片观看四虎永久
人妻少妇精品免费无码专区v
亚洲另类无码一区二区三区
浮妇高潮喷白浆视频
扒开双腿猛进入喷水高潮叫声
国产成人av电影在线观看第一页
久久亚洲色WWW成人欧美
国产高清一级毛片视频直播
天天天日日日夜夜夜夜摸
人妻无码中字在线a
国产精品亚洲va在线观看
2021年一级A片免费视频
一级成人a毛片免费播放
亚洲欧洲精品日韩av
爱豆传媒AV片
免费无码专区毛片高潮喷水
国产又大又猛的三级视频
中文字幕日本在线视频二区
国产成人一区二区三区在线观看
欧美精品亚洲精品日韩专区va
国产福利影院在线观看
国产又色又刺激高潮免费看
午夜福利在线观看视频
婷婷97狠狠做五月深爱婷婷
熟妇人妻久久精品一区
国产在线无码一区二区三区
高清高速无码一区二区
国产私拍大尺度在线视频
欧美肏屄视频
久久久久久久波多野结衣高潮
撕开奶罩揉吮奶头高潮AV
强奷白丝美女在线观看
免费播放一区二区三区四区
成年av福利永久免费观看
日本道色综合久久影院
AV色网站青青草
久久久久亚洲AV成人网人人软件
久久久久久免费视频
97se亚洲国产综合自在线观看
亚洲红杏AV无码专区首页
亚洲国产精品乱码一区二区三区
一本大道AV伊人久久综合
国产乱人乱偷精品视频a人人澡
亚洲综合日韩久久成人AV
亚洲国产精品午夜电影
日韩亚洲中字无码一区二区三区
999精品视频在线
韩国AV一区二区
亚洲vα中文字幕123
中文字幕无码AV不卡一区
中文字幕午夜五月一二
国产亚洲精品日韩香蕉网
重口调教一区二区视频
欧洲极品无码一区二区三区
国产成人综合亚洲网
亚洲一区二区偷拍怎么找
狠狠狠狠狠
国产乱人伦APP精品久久
爱爱福利导航
狠狠操在线观看
免费国产黄网站在线观看动图
欧美一区二区精品
日韩另类综合自拍亚洲
久久久久国产一级毛片高清版
曰本女人牲交全视频免费播放
国产精品女同一区二区久久
亚洲欧美日韩精品
文中字幕一区二区三区视频播放
欧美日韩激情在线一区二区
欧美在线视频不卡第一页
久久久久久亚洲精品中文字幕
99热成人精品热久久66
亚洲人成网站观看在线播放
精品国产成人国产在线观看
啄木乌AV无码精品
久久久国产精品视频
无码国产精品一区二区免费式影视
中文字幕一区二区日韩
国产乱人伦偷精品视频色欲
在线天堂av一区二区
国产精品久久久久尤物
欧美老熟妇乱子伦牲交视频
V一区无码内射国产
欧美成人一区二区三区
精品处破女学生
无码AV高清毛片中国一级毛片
无码专区av
天天视频黄色在线观看完整
亚洲AV综合色无码国产精品四季
日韩色哟哟
免费A级毛片无码A∨性按摩
亚洲欧洲国产经精品香蕉网
国产乱人伦偷精品视频色欲
丝袜美女国产精品一区二区
国产欧美精品区一区二区三区
欧洲美妇乱人伦视频网站
成人cosplay福利网站18禁
欧美精品福利
亚洲VA欧美VA国产VA综合
青青草原亚洲在线视频
水蜜桃视频在线观看免费18
色噜噜狠狠一区二区三区果冻
欧洲中文字幕国产精品
国产精品无需播放器在线观看
中文字幕日本在线免费
丰满的少妇人妻无码区
色噜噜狠狠色综合成人网
东京热人妻系列无码专区
青青草原精品99久久精品66
99在线国内在线视频22
99久久亚洲精品影院
综合性爱网
欧美日韩免费一区中文字幕
婷婷五月六月激情综合色中文字幕
久久久久婷婷国产综合青草
永久免费观看的毛片视频
九九线精品视频在线观看
人妻熟妇乱又伦精品视频
av精选在线观看精品
亚洲AV产在线精品亚洲第一站
成人无码av一区二区三区
亚洲精品国产V片在线观看
成年奭片免费观看视频天天看
久久66久6这里只有精品
国产美女视频一区二区三区
国产在线无码一区二区三区
亚洲精品成人黄色av
日韩aV无码午夜
亚洲成人av在线高清
久久亚洲午夜牛牛影视
欧洲精品卡1区2卡三卡四卡
日本免费一区二区久久人人澡
欧美中文字幕无线码视频
99精品视频免费
国产成人精品无码一区二
四虎无码精品a∨在线观看
91资源五区
韩国午夜三级一区二区
国产微拍一区二区三区四区
久久18禁高潮出水呻吟娇
国产精品一区二区主播
AV无码观看
国产欧美综合在线观看第十页
久久久久99精品成人片试看
国产毛片三区二区一区
亚洲一区二区三区首页
A级毛片不卡在线播放
丰满人妻熟妇乱又伦精品软件
中文字幕有码高清日韩
亚洲中文字幕在线无码一区二区
成年女人喷潮免费视频
香蕉草草久在视频在线播放
在线观看91精品国产秒播
国产亚洲精品久久麻豆
国产一区二区三区av在线无码观看
成人网站在线
黄页网址大全免费观看美女
日韩中文字幕一区二区高清
好男人社区影视在线WWW
天天拍天天操
在线免费播放av观看
超碰色色
欧美xxxx做受欧美.88
真实国产乱子伦对白视频
亚洲AV无码专区在线观看素人
久久亚洲国产成人亚
亚洲24小时在线免费视频网站
人人爱天天做夜夜爽
亚洲中文字幕有综合久久
开心一区二区三区激情
精品久久精品久久人妻
亚洲成人77777
婷婷久久综合九色综合97最多收藏
精品三级av
亚洲人无码XXXX
国产福利深夜在线播放
日韩精品亚洲精品485页
亚洲午夜精品a片一区二区app
欧美视频二区在线观看
性欧美视频
亚洲熟女片嫩草影院
亚洲国产97在线精品一区
国产又黄又湿又刺激网站
国产精品吹潮在线观看中文
欧美a级欧美1级a大片
www.操.c
国产伦久视频免费观看视频
桃花岛–人妻
日本三级黄
91视频免费观看网站
欧美乱妇狂野欧美在线视频
精品一区二区亚洲国产
国产亚洲人成网站在线观看l
国产精品自拍自在自线
女人十八毛片免费特黄
免费看91的网站
99er这里只有精品
亚洲日韩Av一区二区三区中文
国产日韩精品在线视频
永久福利盒子日韩日韩免费看
色综合久久网女同蕾丝边
激情五月天婷婷
亚洲成a人v欧美综合天堂软件
国产三级自拍视频在线
久久久久AV无码免费网
国产一区中文字幕手机在线
四虎永久精品免费视频
黄色网址在线播放
欧美国产日韩一区二区三区精品影视
国产亚洲精aa在线观看不卡
91色色色
日韩欧美中文字幕在线播放
亚洲VA无码专区国产乱码
亚洲 暴爽 AV人人爽日日碰
免费看少妇作爱视频
中文字幕久久久久人妻无码
国产福利私拍在线永久视频
亚洲性爱区免费视频一区
啊灬啊灬啊灬快灬高潮了
亚洲日本偷拍中文字幕
中文字幕乱码无码人妻系列蜜桃
精品无码一区二区三区爱欲小说
日韩不卡视频在线观看
久久国产精品成人影院
色欲国产一区二区日韩欧美
久久天天躁夜夜躁狠狠85台湾
啪啪啪啪网站
深夜国产成人福利在线观看
狠狠色综合网站久久久久久久
国内精品自在欧美一区
亚洲aⅴ永久无码精品毛片
日韩精品久久久免费观看
国产又色又爽无遮挡免费动态图
欧美国产日韩A在线观看
女人让男人桶爽30分钟小视频免费
99re热视频精品免费观看
人人狠狠久久亚洲综合88
狠狠色狠狠综合久久
在线观看亚洲欧美日本
男女肉粗暴进来动态图
aa精品视频在线在线观看免费
欧洲天堂一区二区
亚洲AV无码成人网站久久精品
色偷偷男人的天堂亚洲av
拍真实国产伦偷精品
欧美性交
欧美性爱在线免费观看
国产日韩一区二区三免费高清
宅男撸
久久综合给合久久狠狠狠…
91蜜桃麻豆
天天看片视频免费观看
中文字幕日本在线免费
国产办公室秘书无码精品99
国产超碰AV人人做人人爽
av无码男人天堂
国产熟女亚洲精品麻豆
啄木乌AV无码精品
久久亚洲av熟女国产
日韩av二区三区一区
好男人精品无码
日韩AV无遮挡污污在线播放
成人免费黄色小视频
欧美囗交xx×bbb视频
91国际精品麻豆视频
高颜值国产女主播在线
香蕉视频在线观看黄
福利视频一区二区在线
亚洲丁香五月天
国内精品自线在拍
在线欧美中文字幕农村电影
国模无码人体一区二区
亚洲一区二区三区影院
亚洲欧美成aⅴ人在线观看
国产黄片一区视频在线观看
国产乱子伦农村xxxx
18禁无遮挡国产免费观看
国产边摸边吃奶边做爽视频
国产成人久久精品流白浆
在线国产毛片手机小视频
日韩福利导航
亚洲AV电影不卡在线观看
精品二区二区三区
中文字幕日韩精品人妻在线第一区
亚洲永久一区二区三区在线
亚洲国产一线二线三线
欧美全免费aaaaaa特黄在线
国产成人一区二区三区视频免费
国产精品成人亚洲777
完整在线视频免费黄片
岛国大片av在线观看
99国产精品国产高清一区二区
婷婷五月综合网
超碰97人人做人人爱综合
中文字幕亚洲综合久久综合
久久100@
日本一极品久久99精品
91国在线啪精品一区
国产拳交
日韩欧美综合在线
婷婷色综合成人成人网小说
色呦呦手机在线精品
91精品国产自产91精品资源
久久人妻天天av
国产精品成人一区二区
亚洲国产成人久久综合一区
日韩欧美在线观看一区二区视频
人妻AV无码系列一区二区三区
久久婷婷五月综合97色
业余自由性别视频视频
欧美一区二区精品
国产乱人伦APP精品久久
国产午夜一级鲁丝片
亚洲日本中文字幕天堂网
久热这里只有精品视频6
少妇下面好紧好多水真爽播放
国产精品一二三区
在线观看污网站
久操超碰
亚洲高清一区二区三区久久
污污网站在线看
久久99爰这里有精品国产
欧洲精品99毛片免费高清观看
亚洲日本中文字幕天堂网
国产综合在线视频_亚洲日韩在线观
精品视频无码
亚洲国产亚洲综合在线尤物
伊人久久国产免费观看视频
亚洲AV无码国产精品色午夜软件
国产久久一级
尤物yw午夜国产精品大臿蕉
一级毛片免费观看视频
国产无套精品一区二区三区
中文字幕被公侵犯的漂亮人妻
国产小视频在线播放
精品女同一区二区三区免费站
国产voyeur精品偷窥222
国精产品一区一区三区mba下载
亚洲伊人久久综合影院
很很鲁很很很鲁在线视频播放
色噜噜久久综合伊人一本
免费岛国大片在线播放
三级网站在线免费观看
久久精品成人免费国产
日韩久久久久久
精品久久杨幂国产杨幂
99久久伊人精品综合观看
免费看无码自慰一区二区
亚洲天堂久久一区av
国产免费AV片在线看
国产永久福利?在线
91精品91久久久中77777
免费看AV毛片一区二区三区
国产初高中生视频在线观看
91在线视频观看
久久综合九色综合欧美就去吻
精品蜜桃视频在线观看
国产成人精品成人A在线观看
国产年成美女网站视频免费看
亚洲国产一成人久久精品
日日摸夜夜添夜夜添无码视频夫区
国产在线观看综合91
视频一区二区三区国产
91丝袜美腿高跟国产老师在线
国产AV影片麻豆精品传媒
国产日韩高清av在线观看
国产高潮流白浆喷水免费a片
中文字幕高清无码不卡在线
欧美日韩在大午夜爽爽影院
精品一久久香蕉国产线看观
一本大道在线一久道一区二区
亚洲欧美日韩在线精品一区二区
久久精品视频九九店
成人av在线一区二区
亚洲国产麻豆综合一区
宅男久久精品国产亚洲av麻豆
AV边做边流奶水无码免费
999国内精品永久免费视频
日日摸夜夜添夜夜添无码视频夫区
亚洲国产精品免费在线观看
久久天天躁狠狠躁夜夜2020老熟妇
久久久久无码精品国产不卡
一区二区三区精品偷拍
天天天天操
欧美国产日韩在线播放
成人国产亚洲精品a区天堂
白丝精品一区二区三区
亚洲精品动漫在线观看
精品国产三级在线观看
国产一区丝袜在线播放
韩国av一区二区
久久av无码精品人妻系列
亚洲国产老鸭窝一区二区三区
丰满人妻熟妇乱又伦精品视频三
亚洲色avav
日日狠狠久久8888偷偷色
樱花草在线影视WWW中文字幕
亚洲嘿嘿视频在线观看
日韩中文字幕精品人妻
五月婷婷网
亚洲国产成人aⅴ毛片大全
日韩精品亚洲精品485页
一本色道久久综合无码欧美
操碰在线观看
99久久国语露脸精品国产
亚洲阿v天堂网2021
国产日产欧产精品精品蜜芽
久久久久久影院久久
亚洲成A人片在线观看你懂的
精品视频一区二区三区免费看
国产av最新一区二区
国产1024在线永久免费观看
在线播放深夜精品三级
欧美日韩综合在线
一本到综在合线伊人
成人福利
欧美亚洲另类一区二区三区
日韩免费精品一级毛片
亚洲欧洲中文日韩AV乱码
国产乱理伦片在线观看
影音先锋5566夜色资源网
98福利国产在线观看午夜天堂
亚洲熟妇色xxxxx欧美老妇
人妻日韩人妻中文字幕
日韩成人网上操叉不卡
日韩精品一区二区亚洲AV观看
国产欧美精品区一区二区三区
国产产无码乱码精品久久鸭
99久久国产成人免费网站
国产ts在线视频专区
久久这里只有经典29
亚洲AV日韩AV永久无码网站
综合成人
亚洲欧美日韩高清中文
五月婷婷五月天
中文字幕日韩一二三区
日韩特黄无码A片免费视频
k频道国产在线观看
午夜国产精品久久影院
97热
国产精品亚洲中文字幕
婷婷五月综合人人网
国产精成人品日日拍夜夜
国产成人精品免费视频大全五级
精品久久精品久久人妻
久久这里只精品国产2
亚洲国产一区二区A毛片
在线观看国产小视频
亚洲欧美日韩第三区
国产啪精品视频网站免
特黄特色的大片观看免费视频
久久99精品久久久久久9
国产成人综合手机在线播放
青青青国产在线观看手机免费
国产精品福利在线观看秒播
曰韩无码
真实国产网爆门事件在线观看
WWWW狠狠操夜夜操天天操
最近最新2019中文字幕高清
自拍偷自拍亚洲精品情侣
九九热无码
久久久橹橹橹久久久久
色综合色天天久久婷婷基地
久久精品中文字幕少妇
日韩精品视频一区二区三区
呦交小U女精品视频
亚洲一级毛片在线播放
手机在线看永久AV片免费
无遮挡免费高清羞羞视频
亚洲欧美日韩www
少妇被粗大的猛烈进出动视频
女教师娇喘潮喷抽搐在线视频
在线日本国产成人免费的
天天躁日日躁狠狠躁日日躁
国产精品成人无码a 无码
亚洲中文在线一区二区
福利姬导航在线观看
亚洲国产精品ⅴa在线播放
亚洲私人无码综合久久网
男女男精品网站在线观看
亚洲综合色自拍一区
精品免费人伦一区二区三区蜜桃
国产精品VA在线观看老妇女
国产高清女人对白av在在线
四虎永久在线精品免费AV
成本人妻片无码中文字幕免费
日韩无码真实干出血视频
久久人人爽人人爽大片aw
久久久精品免费国产四虎
国产欧美国产综合每日更新
无码ol丝袜高跟秘书在线观看
青青青操
91麻豆国产香蕉久久精品
国产午夜精品成人在线
黑人VideOS特大粗暴
青草视频在线观看入口
精品国产高清中文字幕
91无码人妻精品一区
精品中文人妻在线不卡
日日摸天天爽天天爽视频
久久亚洲AV无码精品色午夜麻
乱码精品国产一区二区
亚洲精品色情aⅴ色戒
18禁成人免费无码网站
国产成人av综合亚洲色欲、、
国产亚洲AV综合人人澡精品
日本一区二区三区不卡高清视频
国产精品 亚洲一区二区三区
手机在线看永久AV片免费
日韩av无码精品
变态另类第一页
国产成人免费高清在线观看
国产在线拍偷自揄观看视频网站
国产成人久久精品流白浆
国产高清在线A免费视频观看
无码AV高清毛片中国一级毛片
亚洲熟妇AV乱码在线观看
二级特黄绝大片免费视频大片
亚洲中文波霸中文字幕
国产在线精品福利大全
成人精品视频一区二区不卡
黄片福利社
免费人成在线观看视频无码
国产AV无码专区亚洲AV中文
亚洲国产亚洲综合在线尤物
欧美一区二区视频三区
国产偷国产偷精品高清尤物
亚洲碰碰人人av熟女天堂
思思久久精品一本到99热
天天爱天天做天天爽夜夜揉
五月综合激情久久婷婷
亚洲色大成网站WWW国产
韩国无码AV片在线观看网站
精品国产日韩专区欧美第一页
米奇精品一区二区三区
亚洲一区二区偷拍精品
丝袜美腿亚洲一区二区
亚洲中文字幕一区二区不卡
亚洲无码天堂
精品人妻系列无码专区久久
AV麻豆天堂
久久亚洲午夜牛牛影视
亚洲中文无码成人影院在线播放
国产人妖xxxx做受视频
国产成人精品久久综合
亚洲精品色情aⅴ色戒
強壮公弄得我次次高潮A片
国产精品1区2区3区在线播放
天天操夜夜操
亚洲熟妇夜夜一区二区三区
天天狠狠操
亚洲一二三四五区视频
亚洲欧洲国产精品自拍
久久国产精品免费一区下载
精品日韩免费在线观看
在线观看国产小视频
蜜臀av一区二区国产在线
国产精品成人av电影不卡
欧美精品三级
精品精品国产理论在线观看
国产卡一卡二卡三卡四100
国产久草免视频
中文字幕人妻av一区二区
成人亚洲欧美激情在线电影
国精品人妻无码一区二区三区性色
欧美成人精品激情在线观看
成人AV网站亚洲
国产超碰无码最新上传
色网站免费在线观看
福利社午夜影院
熟女一区
欧美三级大片
国产最新视频一区二区
久久精品色妇熟女丰满
久久久婷婷亚洲5月97色
东北妇女xx做爰视频
在线播放免费av大片
福利社影院
亚洲永久精品唐人导航网址
97色色网
欧洲av在线不卡s
国产乱弄免费视频观看
亚洲AⅤ无码一区二区三区
永久在线精品免费视频观看
中文字幕日韩高清一区
日韩精品乱码AV一区二区
亚洲色吧Av
www.东京热.com
人人人澡人人肉久久精品
国产成人av性色在线影院色戒
少妇人妻无码永久免费视频
精品欧美一区二区精品久久
国产免费久久精品99re不卡
亚洲精品女主播麻豆久久91
日本A级网站
中文字幕亚洲乱码熟女一区二区
国产精品久久久久久亚洲影视
欧美日韩一区二区三区韩大
精品无码久久久久久久久水蜜桃
日本怡春院一区二区三区
亚洲 欧美 日韩 综合aⅴ
久操资源
国产精品毛片在线更新
免费看又黄又爽又猛的视频软件
国产色噜噜噜在线精品
日韩精品一区二区亚洲AV观看
日本三级在线播放线观看视频
国产成人成人一区二区
一级a性色生活片久久无码
国产精品一品二区三区的使用体验
日韩av无码精品
a片无码高清免费视频播放
免费天堂网av手机版
小说区图片区综合久久亚洲
美女视频黄a视频免费全过程
2025精品偷拍视频
国产精品手机在线观看你懂的
亚洲国模精品一区二区
亚洲精品无码日韩国产不卡av
三级A片
欧美中文字幕一区二区三区
国产在线三级自拍视频
国产无遮挡又黄又爽动态图
国产熟女AAV久久
国产美女a做受大片免费
国内av在线观看播放
亚洲国产成人久久一区WWW
撕开奶罩揉吮奶头高潮AV
无码专区AAAAAA免费视频
久久这里只有经典29
福利一区一区二区刺激
亚洲国产综合91麻豆
777米奇色狠狠俺去啊
久久精品国产免费观看三人同眠
色综合久久久久无码网
亚洲日本国产综合高清醉红楼
91社视频
亚洲精品在线国产精品
亚洲成综合人影院在院播放
天天日狠狠操
亚洲AV永久无码精品导航
人妻少妇av中文字幕乱码
中文字幕亚洲综合久久综合
国产午夜福利免费入口
国产成人高清精品亚洲
色AV综合AV综合无码网站
久久久久亚洲Av片无码一区
成人精品日日摸夜夜爽
精品无码成人网站久久久久久
人人妻人人澡人人爽欧美二区
黑巨人与欧美精品一区
激情综合色综合啪啪五月丁香
国产成人精品一区二免费网站
日韩午夜高清福利片在线观看
四虎国产精品永久在线国在线
欧美和黑人XXXX猛交视频
久操B网
婷婷六月在线精品免费视频观看
爱豆传媒AV片
久久国语露脸精品国产麻豆
亚洲国产另类久久久精品
欧洲亚洲欧美国产日本高清
国产精品女人在线观看
伊人精品久久久大香线蕉
国产激情内射在线影院
欧美性交
波多野结衣爽到高潮漏水大喷
一本久道综合在线无码88
肏屄欧美
WWW.黄色
日韩免费视频一一二区
精品一卡2卡三卡4卡乱码精品视频
国产精品所毛片视频
国产一区丝袜在线播放
国产一区二区福利久久
经典熟女丝袜视频一区
国产福利在线视频尤物tv
国产免费网站看v片在线观看
色噜噜狠狠色综合网图区
丁香五月天堂
国产乱色国产精品免费视频
国产无遮挡18禁无码网站免费
成人福利社
久久精品中文字幕女同
国产午夜精品视频免费不卡
婷婷四房综合激情五月在线
国产一区在线观看无码
av天堂亚洲国产av
日韩www
粉嫩导航
国产福利一区二区在线精品
久久综合九色综合欧美狠狠
性生大片一级毛片免费观看
岛国大片在线免费观看
国产美女自卫慰黄网站
AV色网站青青草
91福利影院
中文字幕亚洲乱码熟女一区二区
国产综合无码一区二区辣椒
亚洲制服无码一区二区三区
国产91丝袜在线播放动漫
瑟瑟久久
国产高清精品在线播放
国产女主播免费在线观看
亚洲AV天天做在线观看
丁香激情六月综合五月
亚洲AV综合AV一区二区三区
国产91久久精品久久精品
欧美片欧美日韩国产综合片
国产视频网
三级黄色片网站
宅男噜噜噜66网永久在线观看
国产无遮挡裸露视频免费
日日撸夜夜撸
暖暖 免费 在线 中文日本
97色色网
色屁屁WWW免费看欧美激情
精品处破视频在线观看
国产午夜亚洲精品不卡网站
亚洲日本精品国产第一区二区
国产一区在线观看无码
国产精品调教视频一区
岛国av免费
国产亚洲成AV人片在线观看导航
操操影院
人妻精品
亚洲三级视频
正在播放国产对白孕妇作爱
yw.193.c㎝国产在线观看
a级毛片毛片免费观看久潮
岛国av一区二区三区
东京热人妻系列无码专区
成人自拍偷拍在线观看
亚洲一区天堂
国产一区二区三级在线
好大好深好猛好爽视频免费
欧美成人色情视频
一区二区三区在线观看日本视频
欧美高清在线视频一区二区
一区二区三区无码不卡无在线
亚洲—本道中文字幕久久66
麻豆精品秘 一区二区三区
青草免费免费观看视频在线
2021久久最新国产精品
风流少妇一区二区三区
日韩亚洲AV无码三区二区不卡
久久国产精品成人免费古装
久久综合色一综合色88
又爽又黄无遮挡高潮视频网站
久久桃花网综合体
内射一区二区精品视频在线观看
欧亚AⅤ
久久99国产乱子伦精品免费
日本一区二区无卡高清视频
91精品最新国内在线播放
91视频免费观看网站
日本道综合一本久久久88
人妻偷拍一区二区三区
日韩精品亚洲专在线电影
ww欧美
少妇高潮无套内谢麻豆传
天天橾夜夜操
日韩精品一区二区在线观看
国产suv精品一区二区四
天天天干夜夜夜操
欧美三级超在线视频
国内夫妻自拍激情视频
国产亚洲精品成人无码精品网站
日本免费一区二区久久人人澡
精品久久亚洲一级α
国产一区免费在线观看
无套内谢少妇高清毛片
日本黄色三级网站
中文字幕有码在线亚洲
久久综合九色综合97伊人
综合色网亚洲
亚洲欧美日韩中文字幕一区二区
精品久久久无码中文字幕边打电话
亚洲视频在线观看一区二区三
成人生活片一区二区
岛国片免费在线观看
日韩av中文字幕有码
天天做人人爱夜夜爽2020
久久天天躁狠狠躁夜夜网站
国产精品卡1卡2卡3网站
国产av天堂亚洲国产av麻豆
男女猛烈无遮挡午夜视频
a 'v片欧美日韩在线